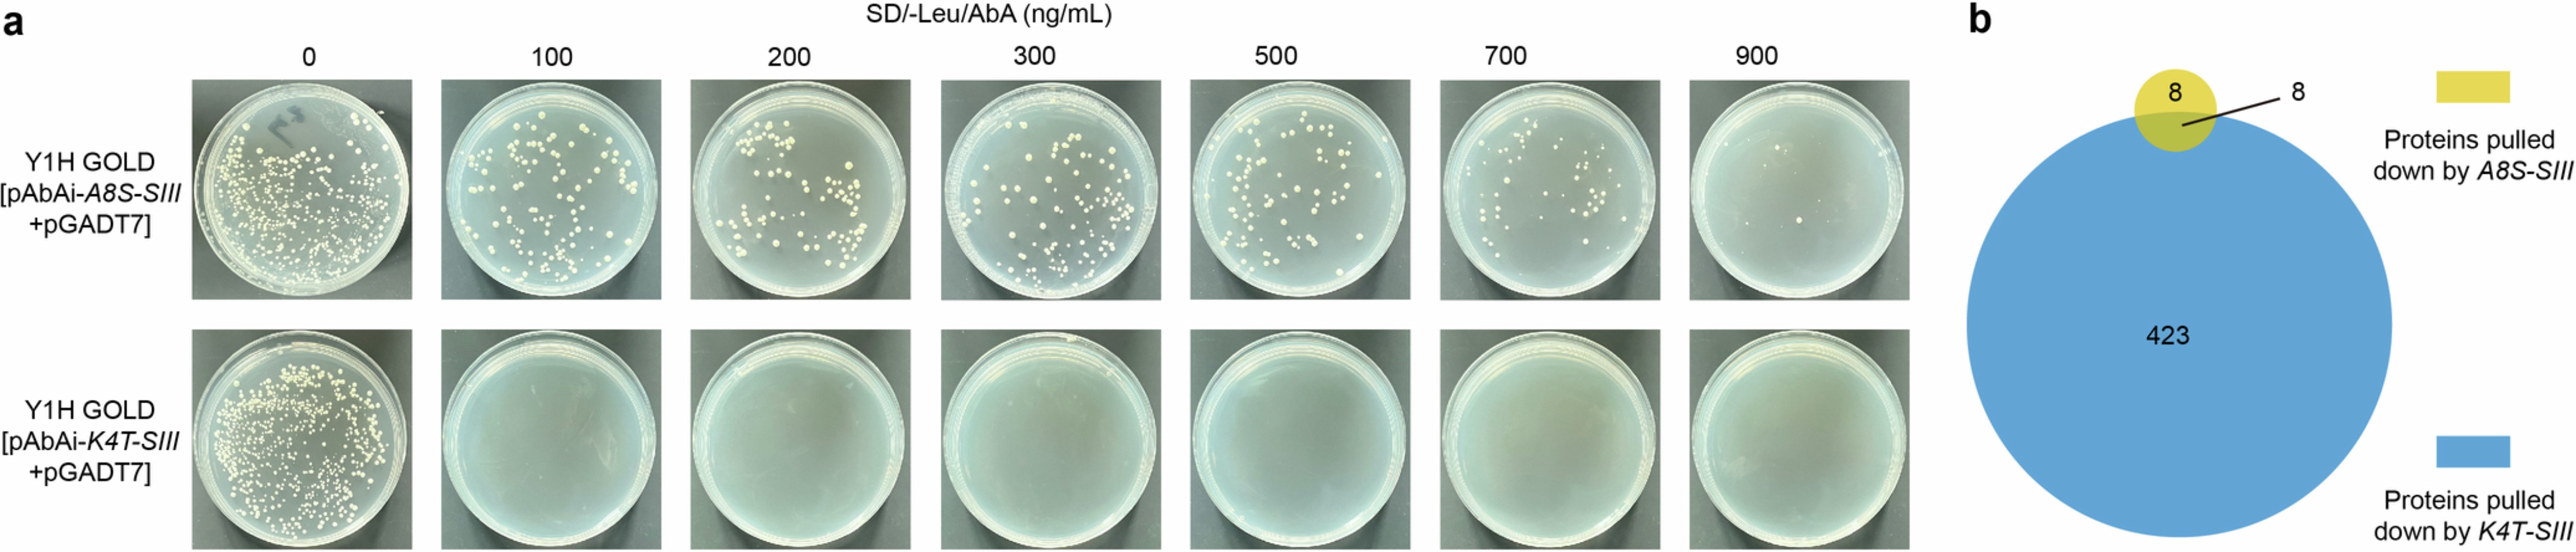
Extended Data Fig. 10: The auto-activation and DNA pull down assays for K4T-SIII and A8S-SIII.

Extended Data Fig. 10: The auto-activation and DNA pull down assays for K4T-SIII and A8S-SIII.
From: TaHST2 silencing shapes basal heat tolerance in allohexaploid wheat
a, Auto-activation assays for K4T-SIII and A8S-SIII. b, Venn diagram showing the numbers of proteins pulled down by K4T-SIII and A8S-SIII.
